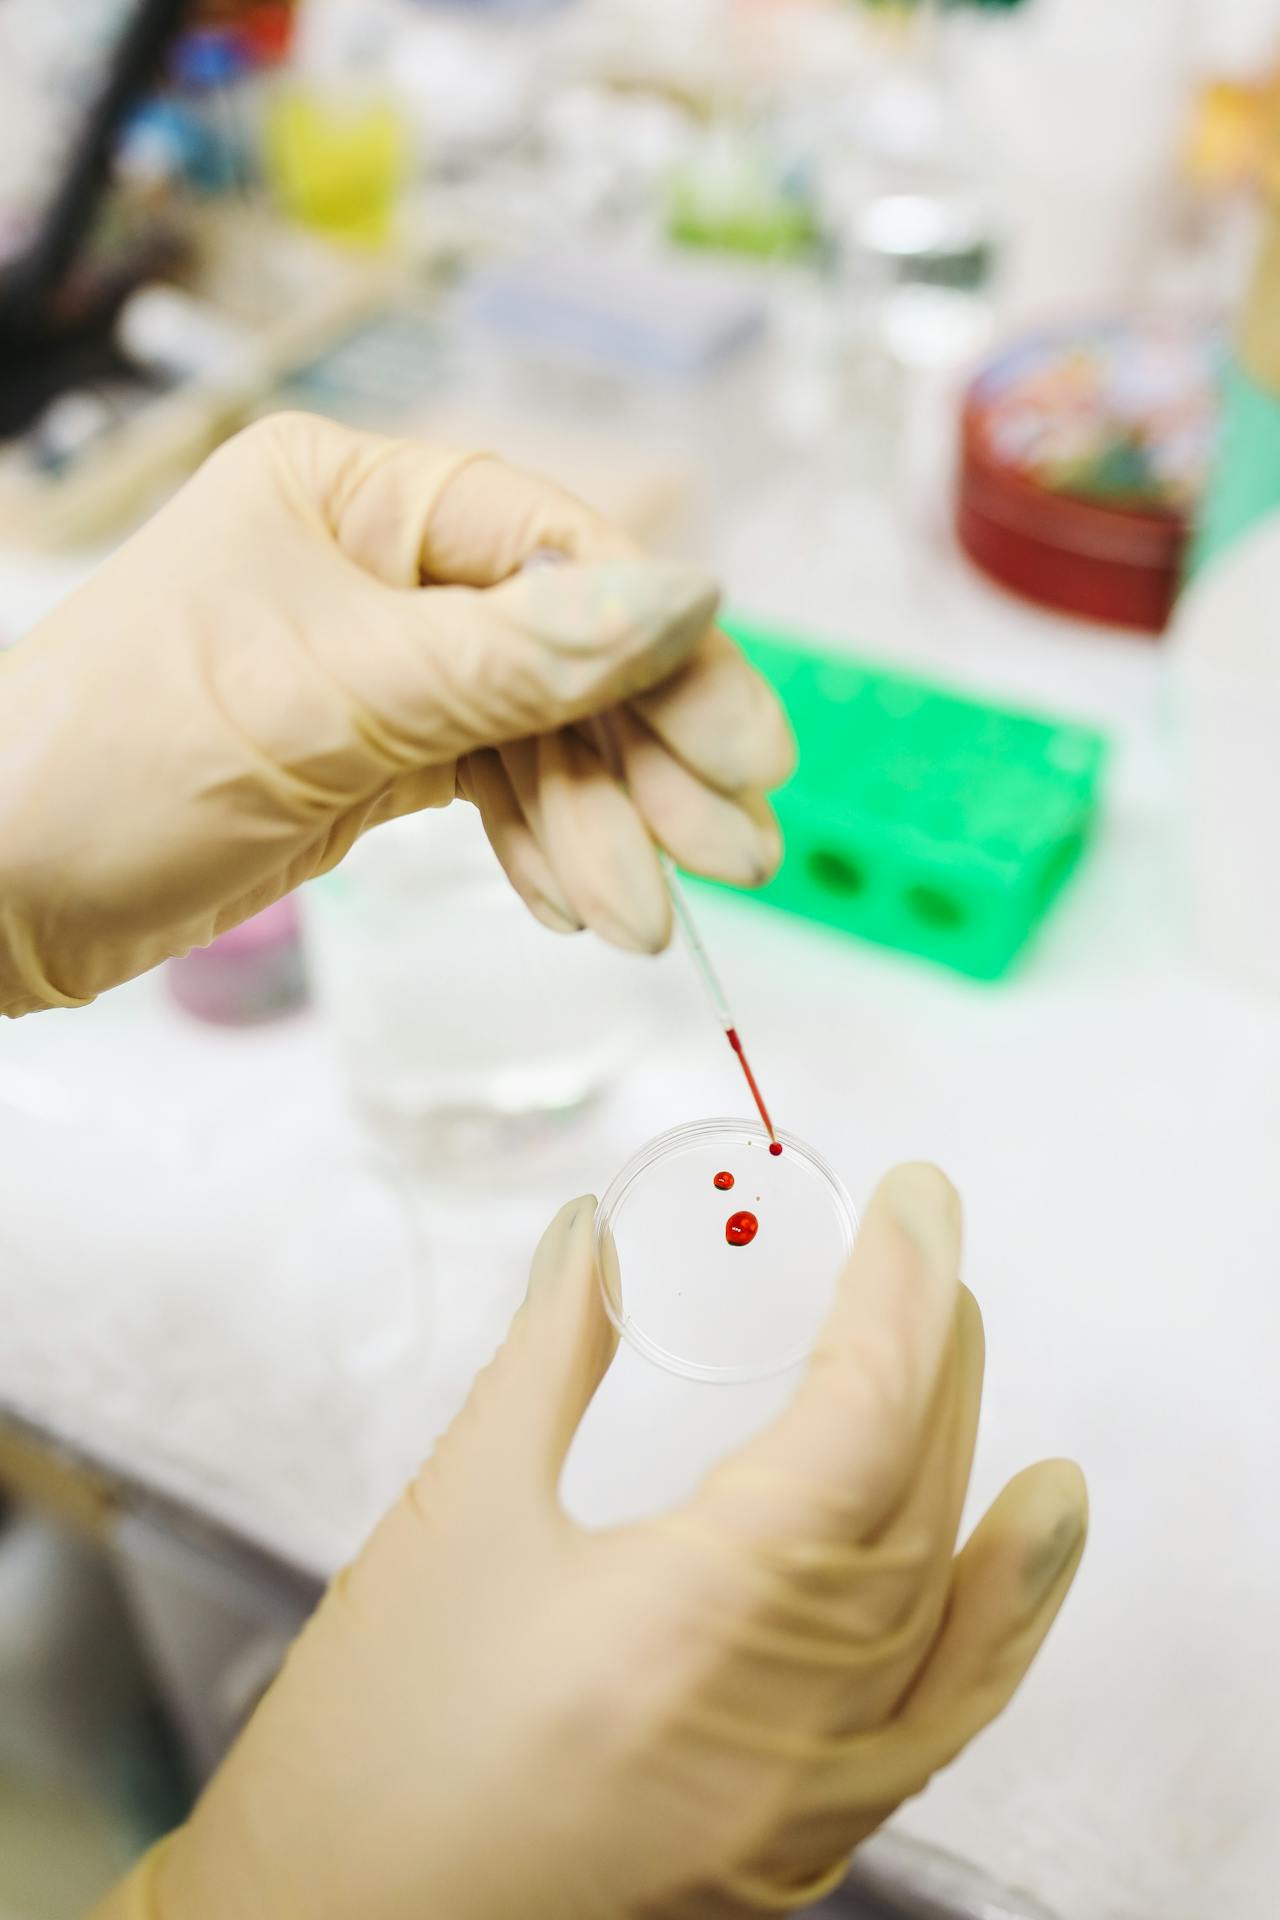

Diversos estudios señalan que mantener una buena salud oral repercute en todo el organismo. Pero, específicamente, una investigación del King’s College London vincula un procedimiento dental con la disminución del riesgo de padecer diabetes y enfermedades cardíacas. Se trata del tratamiento de conducto.
Un tratamiento de conducto es un procedimiento dental que consiste en extraer la pulpa (tejido nervioso y vasos sanguíneos) de un diente infectado o inflamado para salvarlo y aliviar el dolor. El proceso implica limpiar y desinfectar a fondo los canales radiculares. Igualmente, se procede a rellenarlos con un material y luego sellarlos para prevenir futuras infecciones, antes de restaurar el diente con un empaste o corona.
El estudio londinense
Foto: Pexels.com
El análisis de la intervención odontológica se efectuó en el Reino Unido y fue publicado en la revista “Journal of Translational Medicine”. Un equipo de científicos hizo seguimiento a 65 pacientes del Guy’s and St Thomas’ NHS Foundation Trust. Durante dos años examinaron cómo un tratamiento de conducto exitoso influía en la química sanguínea y, como consecuencia, en la salud general, señala la nota referida en el portal de noticias Infobae.
Sadia Niazi, doctora a cargo de la investigación médica, indicó que los hallazgos “muestran que el tratamiento de conducto no solo mejora la salud oral, sino que también puede ayudar a reducir el riesgo de afecciones graves como la diabetes y las enfermedades cardíacas”. Explicó que el estudio se enfocó en pacientes con infección dental común (periodontitis apical). La condición hace que bacterias lleguen al torrente sanguíneo y se incremente la inflamación sistémica.
Niazi explicó que “el estudio empleó espectroscopía de resonancia magnética nuclear (NMR) para analizar moléculas en la sangre de los pacientes”. También, se evaluó “cómo el cuerpo procesa el azúcar, las grasas y otras sustancias clave tras el tratamiento”, reseñó en su web Infobae.

Foto: Pexels.com
Resultados positivos para la salud
Un tratamiento de conducto eficaz se asoció a:
- Mejoras del metabolismo de la glucosa. Durante los dos años de la intervención hubo una disminución significativa del nivel de azúcar en la sangre. Algo favorable para evitar la diabetes.
- Menos inflación. Los marcadores de inflamación principales bajaron. A menudo, estos indicadores se asocian al riesgo cardiovascular y con el paso del tiempo disminuyeron bastante.
- Perfiles lipídicos favorables. A corto plazo, se observó mejoría en los niveles de ácidos grasos y colesterol en sangre. Estos poseen una estrecha vinculación a la salud cardíaca.
